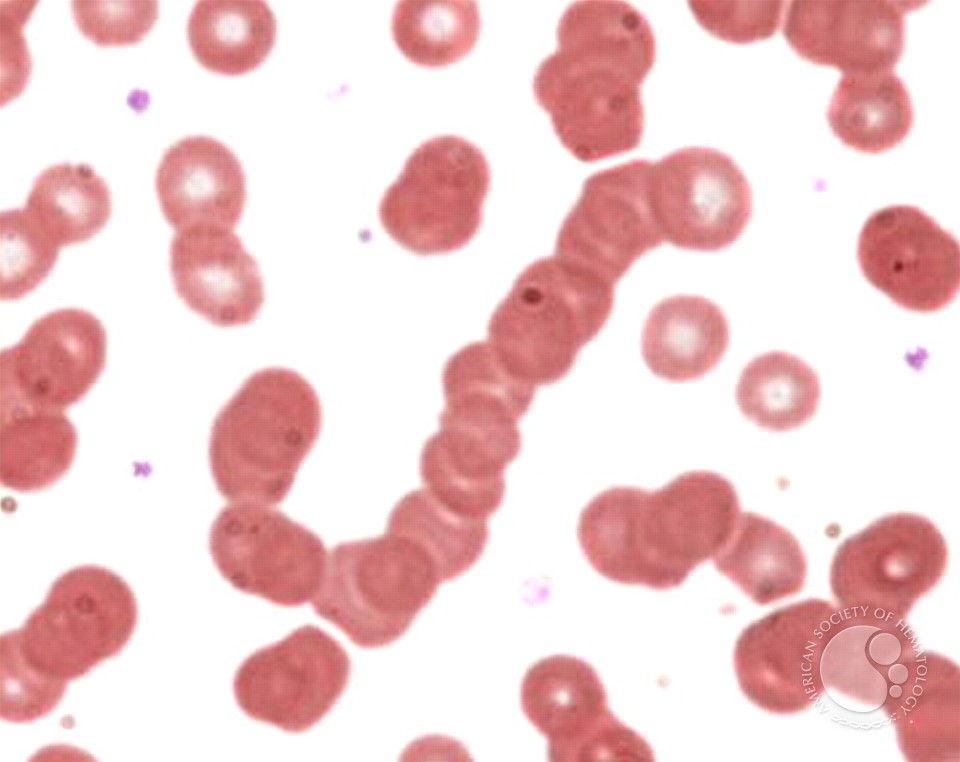
𝗡𝗶𝗵𝗮𝗿 𝗗𝗲𝘀𝗮𝗶 MD, DM tweet media

Dr. sunflower
8.3K posts

Dr. sunflower
@HithTheSpot
PGY1 - M.D anaesthesiology & critical care | yap queen | Van Gogh coded 👩🏽🎨 🪬
Bengaluru, india Katılım Mayıs 2024
411 Takip Edilen2.2K Takipçiler

Yeah well THIS SHIT DID NOT FKN WORK!!!!
Dr. sunflower@HithTheSpot
gonna try “the 12 grapes under the table” thing on new years & let y’all know if it was a myth or a fact next year 😤🧿
English

“Open your mouth as wide as you can”
“Do you have any cough/cold/fever/chest pain/breathlessness?”
parks@parkersity_9
Without naming your job, tell me something you say 20 times per day at work
English

My favourite genre of person is — "Girl sitting on the table next to us at Bob's". Last night some girl approached my friend to take a picture of her and her friends - and then gave us a full Filter Coffee Cheesecake to say thank you.. & im not even surprised bcs that's j how bangaloreans are <3

Nihal@nihilismpro
Went to Bob's after work on Halloween and the girl on the table next to ours asked me if I'm dressed as a Corporate slave 😭
English

@whoisanby Omg congratulations!!!!! So so happy for you! We’ll deserved! 🤍💯
English

To twitters fav @dr_vee95 , and to one of my fav seniors 🤍
congratulations on the MD Anaesthesiology & critical care! 🎉


English

@aditya_gan3500 @DrAkhilX @pankti4299 @MorphologyAmigo @Gaurz3 @NicoGagelmann @GonzaloBentoli1 @Coffeehudigi @OncBrothers They can fix everything 🦴. That's ortro bro for you 🤷🏽♂️
English

@notneharaoo Looks more like burgundy but love the colour on you and the look nonetheless 💓💓💓
English

@hoeezier Why is it called wework? When we don’t want to work 😔
English

@gowda303 Oh hi, long time no seeeeee. How’s prep for finals? 🤡
English